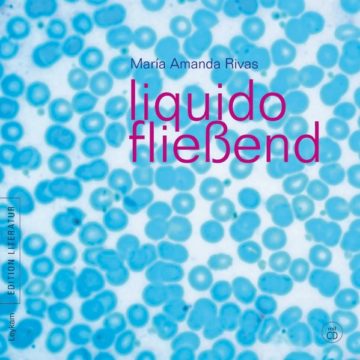

In der Poesie hat María Amanda Rivas einen Weg gefunden, ihre Zerrissenheit zwischen zwei Ländern auszudrücken und darüber hinauszugehen. Die Dichterin und Journalistin verbrachte Kindheit und Jugend in Nicaragua und lebt seit 1978 in Costa Rica. Sie führt in ihrer Lyrik auch in die inneren Welten einer Frau, die sich befreit. Der zweisprachige Band „Líquido“ macht ihr Werk nun erstmals auch einem deutschsprachigen Publikum zugänglich. In der Schauspielerin Ninja Reichert hat die lateinamerikanische Autorin eine kongeniale deutsche Stimme für den Vortrag ihrer Gedichte gefunden. Zu hören auf der beigelegten CD.
- Veröffentlicht am Sonntag 14. Juni 2026 von Leykam
- ISBN: 9783701176335
- 104 Seiten
- Genre: Belletristik, Lyrik